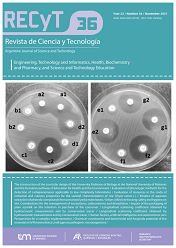
Thumbnail

Ver ítem
- xmlui.general.dspace_homeCentros e Institutos de InvestigaciónCIAP. Centro de Investigaciones AgropecuariasInstituto de Fisiología y Recursos Genéticos VegetalesArtículos científicosxmlui.ArtifactBrowser.ItemViewer.trail
- Inicio
- Centros e Institutos de Investigación
- CIAP. Centro de Investigaciones Agropecuarias
- Instituto de Fisiología y Recursos Genéticos Vegetales
- Artículos científicos
- Ver ítem
Longitudinal scattering coefficient obtained by hydroacoustic measurement and by conservative tracer = Coeficiente de dispersión longitudinal obtenidos por medición hidroacústica y por trazador conservativo
Resumen
Resumen
El objetivo del presente trabajo fue determinar el valor del coeficiente de dispersión longitudinal (DL) del arroyo
Chicamtoltina (Alta Gracia) por medio de dos técnicas diferentes, a fin de comparar los valores obtenidos. La
primera técnica consistió en aplicar una fórmula desarrollada que incluye una descripción detallada de parámetros
hidrodinámicos obtenidos por aforo con un instrumento hidroacústico, mientras que la segunda técnica
[ver mas...]
Resumen
El objetivo del presente trabajo fue determinar el valor del coeficiente de dispersión longitudinal (DL) del arroyo
Chicamtoltina (Alta Gracia) por medio de dos técnicas diferentes, a fin de comparar los valores obtenidos. La
primera técnica consistió en aplicar una fórmula desarrollada que incluye una descripción detallada de parámetros
hidrodinámicos obtenidos por aforo con un instrumento hidroacústico, mientras que la segunda técnica consistió
en inyectar un trazador conservativo, utilizando el mismo enfoque que la teoría de reactores químicos no
ideales de flujo con dispersión. Se trabajó en condiciones de caudal bajo (periodo seco) y en condiciones de alto
caudal (periodo húmedo). Se obtuvo que, ya sea para caudal alto o caudal bajo, los valores del coeficiente de
dispersión obtenidos por ambas técnicas tienen buena concordancia, ajustándose más en periodo seco que en
periodo húmedo. Debido a que en dicho arroyo se realizan compañas de aforo frecuentes, se concluye que ante
características similares de flujo y morfología de la sección, se pueden utilizar los datos del aforo para determinar
el coeficiente DL, a fin de incorporar datos fiables que se aplican a modelos de transporte de contaminantes.
Abstract
The objective of the present work was to determine the value of the longitudinal dispersion coefficient (DL
) of the
Chicamtoltina stream (Alta Gracia) by means of two different techniques, in order to compare the values obtained.
The first technique consisted of applying a developed formula that includes a detailed description of hydrodynamic
parameters obtained by gauging with a hydroacoustic instrument, while the second technique consisted of injecting
a conservative tracer, using the same approach as the non-ideal chemical reactor theory of flow with dispersion.
This work was carried out at low flow conditions (dry period) and at high flow conditions (wet period). It was found
that, either for high flow or low flow, the values of the dispersion coefficient obtained by both techniques have good
agreement, fitting better in the dry period than in the wet period. Due to the fact that frequent gauging campaigns
are carried out in this stream, it is concluded that with similar flow characteristics and morphology of the section,
the gauging data can be used to determine the DL coefficient, in order to incorporate reliable data that can be
applied to pollutant transport model.
[Cerrar]
Autor
Larrosa, Nancy;
Nadal, Ana Florencia;
Diaz Lozada, Jose Manuel;
Babero Medina, Gonzalo Pedro;
Moro, Karen Magali;
Melchiorre, Mariana;
Larrosa, Nancy Beatriz;
Fuente
Revista de CIencia y Tecnología 23 (36): 53-60 (2021)
Fecha
2021
Editorial
Universidad Nacional de Misiones. Facultad de Ciencias Exactas, Químicas y Naturales. Secretaria de Investigación y Posgrado
ISSN
1851-7587
0329-8922
0329-8922
Formato
pdf
Tipo de documento
artículo
Palabras Claves
Derechos de acceso
Abierto
 Excepto donde se diga explicitamente, este item se publica bajo la siguiente descripción: Creative Commons Attribution-NonCommercial-ShareAlike 2.5 Unported (CC BY-NC-SA 2.5)
Excepto donde se diga explicitamente, este item se publica bajo la siguiente descripción: Creative Commons Attribution-NonCommercial-ShareAlike 2.5 Unported (CC BY-NC-SA 2.5)


